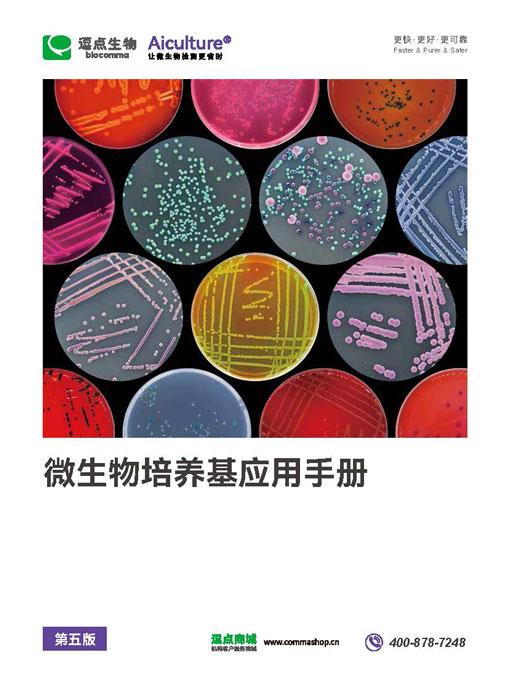

资源中心-疾控及临床检测
- 表面涂抹采样管.pdf 2358MD5
- 微生物运送培养基.pdf 2269MD5
- 微生物产品目录.pdf 1446MD5
- 微生物应用手册20240119.pdf 1429MD5
- 微生物应用手册20240304.pdf 1282MD5
- 微生物应用手册20240415.pdf 1114MD5
- 微生物应用手册20240510.pdf 5006MD5
- 微生物应用手册20240710.pdf 1724MD5
- 微生物培养基应用手册第五版20241107.pdf 5252MD5